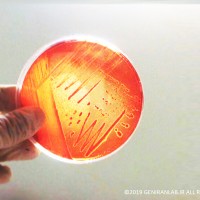
باکتری ها را می توان باتوجه به نیازشان بر روی محیط های کشت ساده یا مغذی رشد داد و یا از آن ها کلونی های ایزوله تهیه کرد پلیت کشت باکتری
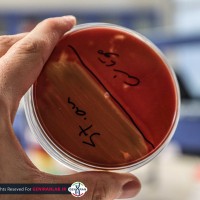
پلیت کشت باکتری
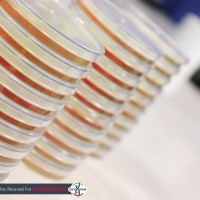
پلیت کشت باکتری
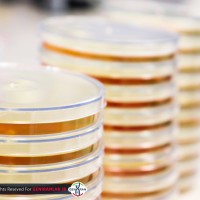
پلیت کشت باکتری

گالری تصاویر
دسته بندی ها
← اتاق حیوانات آزمایشگاه ژنیران با مجهز ترین تجهیزات برای انجام پروژه های تحقیقاتی بر روی مدل های حیوانی.
اتاق حیوانات آزمایشگاه ژنیران با مجهز ترین تجهیزات برای انجام پروژه های تحقیقاتی بر روی مدل های حیوانی. حیوان خانه آزمایشگاه ژنیران فضایی برای انجام تست روی مدل های زنده
حیوان خانه آزمایشگاه ژنیران فضایی برای انجام تست روی مدل های زنده











 استخراج اسیدهای نوکلئیک اولین مرحله ای است که در شروع هر تکنیک مولکولی به آن نیاز داریم.
استخراج اسیدهای نوکلئیک اولین مرحله ای است که در شروع هر تکنیک مولکولی به آن نیاز داریم. سمپلر یا میکروپیپت ابزایست که برای برداشتن مقادیر کمی از هر ماده استفاده میشود.
سمپلر یا میکروپیپت ابزایست که برای برداشتن مقادیر کمی از هر ماده استفاده میشود. دستگاه ترمال سایکلر اصلی ترین ابزار مورد نیاز برای انجام تکنیک PCR است.
دستگاه ترمال سایکلر اصلی ترین ابزار مورد نیاز برای انجام تکنیک PCR است. در آزمایشگاه ها از میکروتیوپ برای ذخیره مقادیر کم نمونه استفاده میشود.
در آزمایشگاه ها از میکروتیوپ برای ذخیره مقادیر کم نمونه استفاده میشود. بشر ظرف استوانه ای است که از آن برای تهیه محلول های آزمایشگاهی استفاده میشود.
بشر ظرف استوانه ای است که از آن برای تهیه محلول های آزمایشگاهی استفاده میشود. ریل تایم پی سی آر تکنیکی است که در آن میتوان واکنش PCR را به طور لحظه ای و کمی مورد بررسی قرار داد.
ریل تایم پی سی آر تکنیکی است که در آن میتوان واکنش PCR را به طور لحظه ای و کمی مورد بررسی قرار داد. یادگیری تکنیک های آزمایشگاهی با شرکت در دوره های کارآموزی طولانی مدت آزمایشگاه تحقیقاتی ژنیران.
یادگیری تکنیک های آزمایشگاهی با شرکت در دوره های کارآموزی طولانی مدت آزمایشگاه تحقیقاتی ژنیران. سانتریفوژ دستگاهیست که از آن برای تفکیک و تهیه رسوب از سرم، محیط های کشت حاوی باکتری و ... استفاده می شود.
سانتریفوژ دستگاهیست که از آن برای تفکیک و تهیه رسوب از سرم، محیط های کشت حاوی باکتری و ... استفاده می شود.

 Real-Time PCR
Real-Time PCR دستگاه Real-Time PCR
دستگاه Real-Time PCR لود کردن روی ژل
لود کردن روی ژل





















 تست MTT نوعی تست سنجس سمیت داروها یا مواد دیگر بر روی سلول های زنده است.
تست MTT نوعی تست سنجس سمیت داروها یا مواد دیگر بر روی سلول های زنده است. تست MTT پرکاربرد ترین تست شناخته شده برای بررسی اثر سمیت داروها یا سایر مکمل های دیگر بروی سلول های زنده است.
تست MTT پرکاربرد ترین تست شناخته شده برای بررسی اثر سمیت داروها یا سایر مکمل های دیگر بروی سلول های زنده است. فالکون آزمایشگاهی لوله ای مدرج برای ذخیره سازی و نگهداری از محلول ها و مواد مختلف است.
فالکون آزمایشگاهی لوله ای مدرج برای ذخیره سازی و نگهداری از محلول ها و مواد مختلف است.







 دستگاه سونیکاتور یک دستگاه هموژنیزه کننده است که از فراصوت برای عملکرد خود استفاده میکند.
دستگاه سونیکاتور یک دستگاه هموژنیزه کننده است که از فراصوت برای عملکرد خود استفاده میکند. SDS PAGE نوعی تکنیک الکتروفورز است که از آن برای جداسازی پروتئین ها استفاده میشود.
SDS PAGE نوعی تکنیک الکتروفورز است که از آن برای جداسازی پروتئین ها استفاده میشود. دوره کارآموزی مهندسی ژنتیک و کلونینگ آزمایشگاه ژنیران با سرفصل های جذاب میزبان شماست.
دوره کارآموزی مهندسی ژنتیک و کلونینگ آزمایشگاه ژنیران با سرفصل های جذاب میزبان شماست.


 محیط های کشت میکروبی انواع مختلفی دارند، که از آن برای تشخیص افتراقی یا کشت انتخابی میکروارگانیسم هایی از جمله باکتری ها استفاده میشود.
محیط های کشت میکروبی انواع مختلفی دارند، که از آن برای تشخیص افتراقی یا کشت انتخابی میکروارگانیسم هایی از جمله باکتری ها استفاده میشود. محیط کشت در میکروب شناسی به صورت مایع یا جامد به کار میروند که آن ها میتوان به صورت پلیت یا لوله ای تهیه کرد.
محیط کشت در میکروب شناسی به صورت مایع یا جامد به کار میروند که آن ها میتوان به صورت پلیت یا لوله ای تهیه کرد. در میکروب شناسی از پلیت های 96 خانه ای می توان برای تست هایی چون MIC و MBC استفاده کرد
در میکروب شناسی از پلیت های 96 خانه ای می توان برای تست هایی چون MIC و MBC استفاده کرد باکتری ها را می توان باتوجه به نیازشان بر روی محیط های کشت ساده یا مغذی رشد داد و یا از آن ها کلونی های ایزوله تهیه کرد
باکتری ها را می توان باتوجه به نیازشان بر روی محیط های کشت ساده یا مغذی رشد داد و یا از آن ها کلونی های ایزوله تهیه کرد

سلام مدرس هم جذب میکنید
آگهی های استخدام مارا در اینستاگرام و یا لینکدین دنبال کنید
بسیارجامع ومفیداست